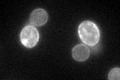
YHR146W
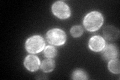
YHR146W

View description
Protein that binds to cruciform DNA structures
Localization:
Intensity:
Fold change:
Significance:
-
C’ GFP library in SD

cell periphery135.01 -
N' NOP1pr-GFP in SD

cell periphery179.466 -
N' TEF2pr-mCherry in SD

cell periphery272.773 -
N' NATIVEpr-GFP in SD

cell periphery85.2262 -
N' TEF2pr-VC and Cyto-VN in SD

cell periphery63.7196 -
C’ GFP library in SD+DTT

cell periphery237.881.76Yes -
C’ GFP library in SD+H2O2
cell periphery137.31.01No -
C’ GFP library in Starvation Media
cell periphery185.541.37No -
C’ GFP library on the background of Pup2-DaMP

cell periphery -
C’ GFP library on the background of CCT mutant

cell periphery111.2590.824053No
